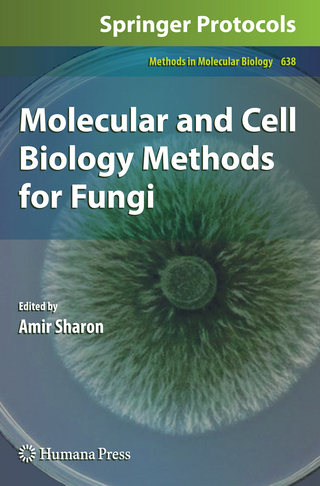
Molecular and Cell Biology Methods for Fungi

Methods and Protocols
Buch | Softcover
2016
|
Humana Press Inc.
ISBN: 9781493949434
CHF 164,75 (inkl. MwSt)
- Versand in
10-15 Tagen